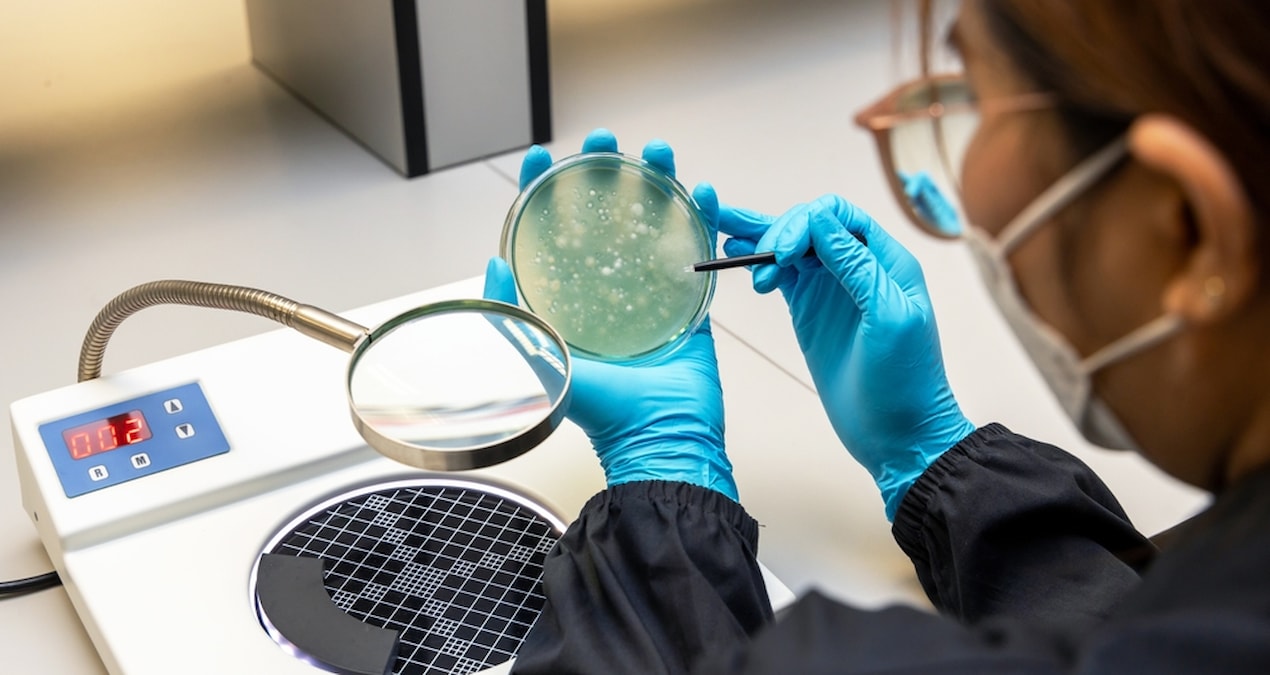

Uzmanlar uyardı… Et yiyen ölümcül bakteri en yüksek seviyede
Japonya’da, yetkililer “et yiyen” bakterinin neden olduğu ve potansiyel ölümcül kabul edilen streptokokal toksik şok sendromu (STSS) vaka sayısının şimdiye kadarki en yüksek seviyeye çıktığını belirterek önlemler için uyarılarda bulundu.
Ulusal Bulaşıcı Hastalıklar Enstitüsü’nden (NIID) yapılan açıklamada, ülkede bu yıl haziran ayının başı itibarıyla STSS vaka sayısının 977’ye ulaştığı ifade edildi. 2023 yılının aynı döneminde 941 vaka görüldüğü, böylece kayıtların tutulmaya başlandığı 1999’dan bu yana vaka sayısının “rekor seviyeye” çıktığı belirtildi.
Hastalığın “streptokok pyogenes” bakterisinden kaynaklandığı ve sıklıkla boğaz ağrısıyla ilişkilendirildiği, takip eden dönemde uzuv nekrozuna ve çoklu organ yetmezliğine neden olabildiği bildirildi.
Bakterinin daha öldürücü ve bulaşıcı türleri kaynaklı enfeksiyon vakalarının özellikle başkent Tokyo merkezli Kanto bölgesinde giderek daha fazla rapor edildiği bilgisi verildi.
COVID-19 tedbirlerinin hafifletildiği 2023 bahar döneminden bu yana vaka sayısında gözlenen artıştan endişe edildiği belirtildi.
Sağlık, Çalışma ve Refah Bakanı Takemi Keizo, gazetecilere NIID’in açıklamasına ilişkin verdiği demeçte, temel enfeksiyon önlemlerinin uygulanmasının önemine işaret ederek, “Enfeksiyon eğilimlerini izlemeye devam etmenin gerekli olduğuna inanıyoruz” dedi.
Tokyo Kadınlar Tıp Üniversitesi’nden Bulaşıcı Hastalıklar Uzmanı Prof. Dr. Kikuçi Ken de özellikle ayak yaralarının streptokokal bakteriyel enfeksiyona karşı hassas olduğunu ifade etti. Kabarcık ve ayak mantarı gibi küçük yaraları bakterinin olası giriş noktası olarak niteleyen Kikuçi, yaşlı hastalarda enfeksiyon kapmadan ölüme kadar geçen sürenin 48 saat olabileceğine dikkati çekti.
Sayıklamanın eşlik ettiği yüksek ateş ve yaraların hızla şişmesinin tehlikeli işaretler olduğunu belirten Kikuçi, böyle bir durumda ivedilikle tıbbi yardım alınması gerektiğini vurguladı. Kikuçi, “Hasta sabah ayağında şişlik fark ettiği anda öğlene doğru dizine kadar genişleyebilir ve 48 saat içinde ölebilir” ifadesini kullandı.
Mie Ulusal Hastanesi Başkanı Taniguçi Kiyosu, mayıs ayında yaptığı açıklamada, söz konusu bakterinin vücuda girmesinin dramatik sonuçlara neden olabileceğini belirterek, yaraların dezenfekte edilmesi ve el yıkama önlemlerinin artırılması çağrısı yapmıştı.
Çoğunlukla 30 yaş civarındaki kişilerde görülen et yiyen bakterinin neden olduğu STSS, “potansiyel ölümcül” olarak nitelendiriliyor.
